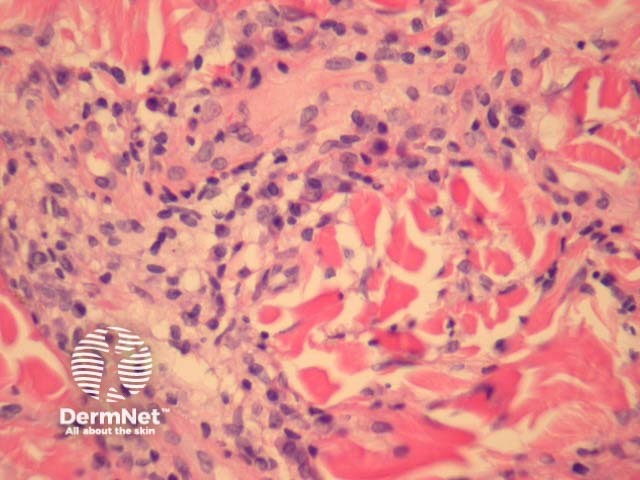
Figure 4

Main menu
Common skin conditions
NEWS
Join DermNet PRO
Read more
Quick links
Infections Diagnosis and testing
Author: Assoc Prof Patrick Emanuel, Dermatopathologist, Auckland, New Zealand, 2013.
Lyme disease is a systemic infection caused by the spirochete Borrelia burgdorferi. Acrodermatitis chronica atrophicans is a late cutaneous form of the disease.
Biopsy of erythema migrans reveals a sparse superficial and deep infiltrate under an uninvolved epidermis (figure 1). Sometimes there is epidermal and/or dermal necrosis. High power examination reveals the infiltrate is mainly lymphocytic (figure 2). There are often sparse eosinophils, admixed plasma cells and mast cells.
Lesions of acrodermatitis chronica atrophicans can show a similar histopathology but the infiltrate is denser (figure 3). The infiltrate consists of lymphocytes and often there are numerous plasma cells (figure 4) admixed with mast cells. There may be impressive superficial sclerosis and fibroplasia.

Figure 1

Figure 2

Figure 3
Figure 4
The borrelia spirochaetes may be identified with silver stains and immunohistochemical methods in some cases. Many cases will be negative with these methods. Polymerase chain reaction (PCR) may also be used.
Insect bite reaction — Lesions of erythema migrans may be non-specific and exactly mimic an insect bite reaction. This is particularly problematic when silver stains and immunohistochemical studies are negative. Clinical correlation, PCR studies, and serologic correlation may be needed.
Sclerosing disorders — Acrodermatitis chronica atrophicans may elicit a sclerosing reaction to closely mimic lichen sclerosus or eosinophilic fasciitis.